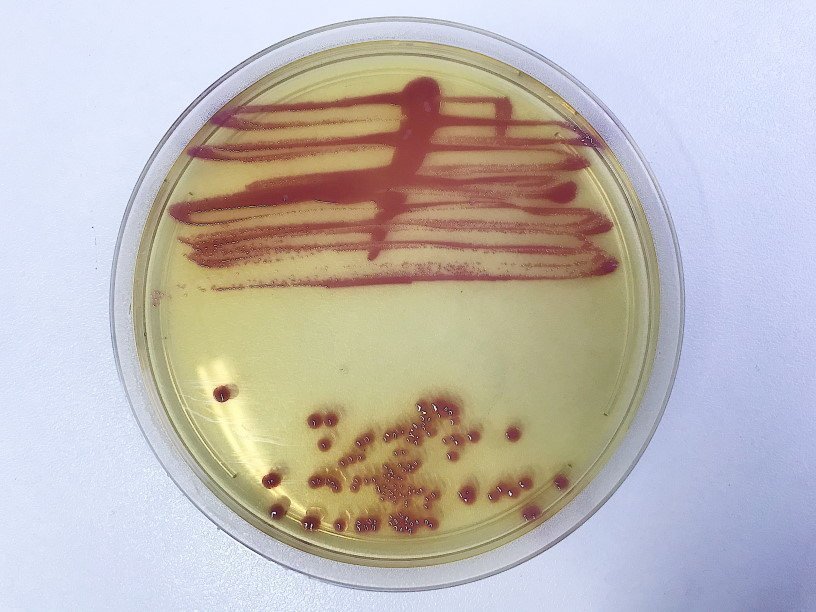

Екатерина Беленко: Промикробы: Сколько вешать в граммах?
Фото: Екатерина Беленко Сдав какую-либо свою биологическую жидкость (или не жидкость) на микробиологический посев, пациент обычно очень ждет результат, а получив его, жутко пугается страшных латинских названий. Но в большинстве бланков результатов есть еще одна немаловажная информация — это количество найденного микроскопического захватчика. Вот посмотрите на фото: на этой чашке Петри — два посева мочи от двух разных пациентов. У них обоих выросла хорошо уже вам известная Escherichia coli. Но разница в ее количестве: в нижней половине чашки — отдельные колонии, а в верхней — сплошной рост. Для некоторых видов анализов существуют нормы, согласно которым меньше определенного количества колоний вообще «не считается». То есть такой результат не означает, что бактерии действительноесть там, где их искали, что именно эти бактерии доставляют пациенту дискомфорт.
⠀
Следить за количеством бактерий, а не только за их качеством, очень важно еще и в случае затянувшейся инфекции. Не всегда же волшебные таблетки помогают молниеносно. Бывает, что лечение помогает, содержание микробного агента снижается, но чтобы это заметить, надо обратить внимание на цифры. Количество бактерий обычно указывают в таком формате, который должен вам напомнить уроки физики в школе, — 10 в некоторой степени. Вот, например, на фотографии сверху — 10 в 6-й степени, а снизу — 10 в 3-й степени. Самые пытливые умы среди моих читателей сейчас должны задать логичный вопрос: 10 в 6-й степени чего? Какова единица измерения? Нашу единицу измерения на уроках физики вы не встречали, она называется КОЕ/мл — сколько в миллилитре колониеобразующих единиц. То есть при размножении одной КОЕ получится одна колония — видимое изолированное скопление представителей одного вида микроорганизмов.
⠀
Вот так у нас все непросто. Один только подсчет крошечных колоний чего стоит. Спасибо товарищу прогрессу, что он не стоит на месте: сейчас достаточно одного приложения и одного смартфона, глаза можно не напрягать. Наводишь камеру на чашку Петри и узнаешь количество колоний за одну секунду. Правда, бывают такие анализы, в которых количественный подсчет невозможен, например, посев крови на стерильность. Этому есть множество причин: содержание микроорганизмов в крови очень низкое, поймать и взрастить их сложнее, чем, например, из мочи. Крови используется больший объем, она культивируется дольше всех других анализов. И в случае, если удалось поймать и вырастить агрессора, невозможно определить, сколько его в пересчете на всю кровь организма. Но лучше пусть ваша кровь всегда будет абсолютно стерильна.
Смотрите также: Екатерина Беленко Промикробы: Все салаты подъедены Екатерина Беленко Промикробы: моча, окутанная мифами Екатерина Беленко Промикробы: Загадочный дисбактериоз Екатерина Беленко Промикробы: Знакомьтесь, синегнойная палочка!